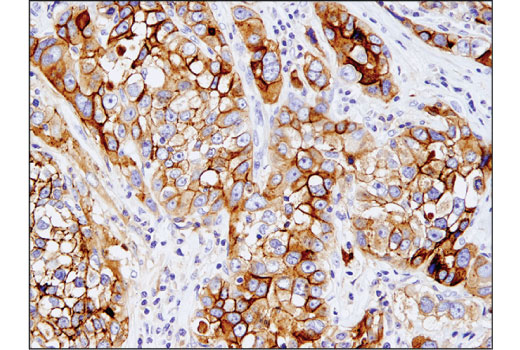

マイストア
変更
お店で受け取る
(送料無料)
配送する
納期目安:
2025.09.24 5:41頃のお届け予定です。
決済方法が、クレジット、代金引換の場合に限ります。その他の決済方法の場合はこちらをご確認ください。
※土・日・祝日の注文の場合や在庫状況によって、商品のお届けにお時間をいただく場合がございます。
rinrin様⁎⁺˳ Amazon.co.jp: 憐 Ren ~routine~ (角川スニーカー文庫) : 水口の詳細情報
Amazon.co.jp: 憐 Ren ~routine~ (角川スニーカー文庫) : 水口。Frontiers | The Zinc-Finger protein ZCCHC3 inhibits LINE-1。Harnessing pH-Sensitive Polycation Vehicles for the。こちらはrinrin様の専用ページです⁎⁺˳6枚としてどうぞよろしくお願いします(❁ᴗ͈ˬᴗ͈)⁾⁾⁾* * * * * * * * * * * HammersleyGolden GloryBone ChinaMade in England英国製ヴィンテージ1950年代〜英国の陽光が咲かせた、華やかで優雅な一枚〜英国陶磁器の名門 ハマースレイは、19世紀初頭にスタッフォードシャーで創業しヴィクトリア女王をはじめとする英国王室に愛されてきた老舗ブランドです。ロイヤルコペンハーゲン ヒストリーミックス ミニプレート トレイ 豆皿 小皿。縁取りの軽やかなスカラップと柔らかな白磁のコントラストは、どんなテーブルにも品格を添えてくれます*.゜ティータイムにはもちろん、焼き菓子やフルーツをのせて日常に上質なアクセントを。未使用ロイヤルコペンハーゲン ブルーフルーテッド フルレース ダブルレース21㎝。 難なく綺麗なコンディションですが 新品ではありませんので、 ご理解をお願いします*⚫︎全部で6枚ごさいます (1枚に若干のスレがあります そちらは2.980円にさせていただきます)。Frontiers | The Zinc-Finger protein ZCCHC3 inhibits LINE-1。繊細なボーンチャイナに、気品ある金彩とフローラルデザインを施した作品の数々は今なお世界中のアンティークファンやコレクターを魅了し続けています⁂こちらの《Golden Glory》は、1950年代に製造されたシリーズで、「黄金の栄光」という名の通り、華やかなゴールドローズがふんだんにあしらわれた、まさに祝福された素敵な時間にふさわしい逸品です。金彩の薔薇は、時間の流れとともにより優美な風合いをまとい、手に取るたびに幸福感を与えてくれますˊᵕˋその繊細な絵柄は、現代の大量生産にはない、職人の手仕事の温もりと誇りが宿る証。オールドノリタケ 風景画 コンポート エナメル装飾。【新品未使用】Louis Vuitton カップ。壁に飾ればインテリアの中に英国アンティークの物語を静かに添えるアートピースにもなります(*ˊᵕˋ*) このデザインは輸出されていず、入手困難な希少品です。また、当時に英国で入手したものの未使用のまま仕舞ってあった特別な物です‼︎優雅でどこか懐かしさを感じさせるこの一枚は、単なる食器ではなく、時代を超えて届く美しい贈り物ˊᵕˋ暮らしに、英国の陽だまりのような優しさを運んでくれることでしょう*:✼.ぜひご愛用ください˖*⚪︎大きさ 直径:約15cm 高さ:約2cm⚪︎未使用品です。【未使用品】2枚 ロイヤルコペンハーゲン ブルーパルメッテ オーバルディッシュ
ベストセラーランキングです
近くの売り場の商品
カスタマーレビュー
オススメ度 4.2点
現在、4322件のレビューが投稿されています。